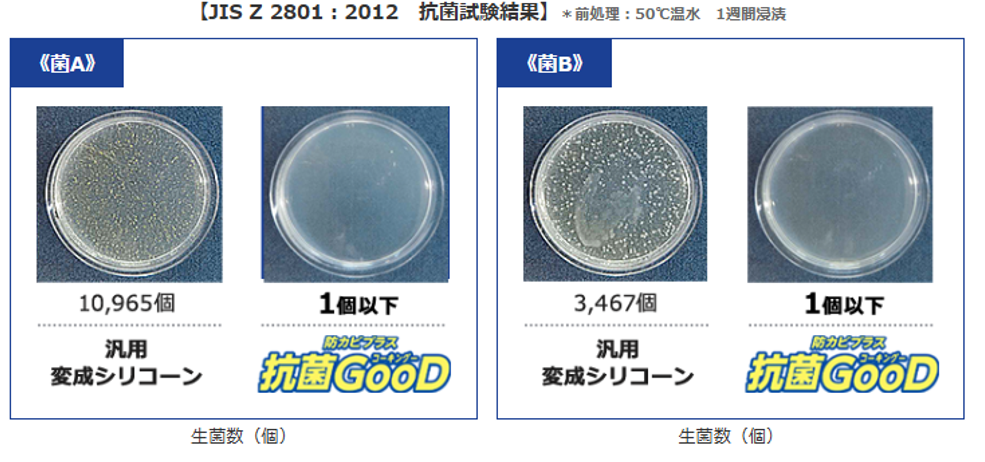

強力防カビ 抗菌GooD!| 防カビ抗菌シーリング材
SIAA抗菌認証取得。抗菌性、防カビ性に優れたシーリング材です。硬化物は高い“弾力性”を保ち、衝撃や振動に強く、被着体同士の膨張・収縮の応力を吸収し、“耐久性”にも優れています。※全ての菌やカビに効果があるわけではありません。
製品特長
①抗菌性能
防カビだけでは満たせない高い抗菌性
②防カビ性能
高い防カビ持続性

使用用途
1.バイオクリーンルーム、病院など、より抗菌特性が求められる建築物の気密、目地シール
2.学校、介護施設、幼児施設、店舗などで使われる抗菌建材の目地シール
3.洗面台やトイレなど、高い抗菌防カビ性能がうれしい水まわりのシール
4.接着剤としても使用が可能です
※軟質塩ビ・ポリエチレン・ポリプロピレン・シリコーンゴム・フッ素樹脂等には、接着しません
※透明ガラス・透明プラスチックなど、接着面に直接、日光が当たる用途には、使用できません




